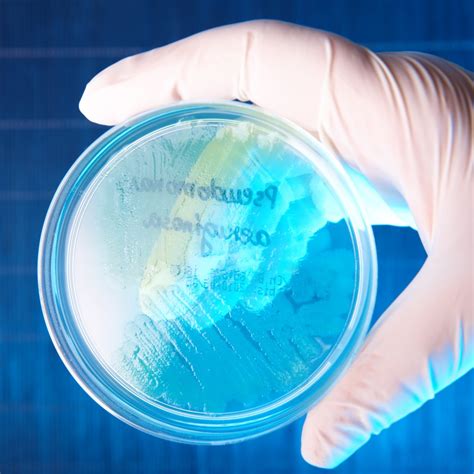

Understanding Pseudomonas Aeruginosa: Classification & Types
Understanding Pseudomonas Aeruginosa: Classification & Types
Hey guys! Ever heard of Pseudomonas aeruginosa ? It’s a type of bacteria that’s pretty common but can sometimes cause serious infections, especially in folks with weakened immune systems. Let’s dive in and explore the classification of *Pseudomonas aeruginosa *, what makes it tick, and the different types you might encounter. We’ll break it down in a way that’s easy to understand, even if you’re not a science whiz.
Table of Contents
What is Pseudomonas Aeruginosa ?
Alright, first things first: What exactly is Pseudomonas aeruginosa ? Simply put, it’s a Gram-negative bacterium. This means it has a specific cell structure that’s a bit different from other bacteria. It’s found just about everywhere – in soil, water, plants, and even in healthy people. However, here’s the kicker: it’s an opportunistic pathogen. This means it usually doesn’t cause problems in healthy individuals. But, if you’re hospitalized, have a weakened immune system (due to conditions like HIV/AIDS or cancer), or have wounds, it can become a serious issue. Pseudomonas aeruginosa loves damp environments, so it can thrive in things like hospital equipment, sinks, and even swimming pools. When it infects someone, it can lead to various infections, ranging from skin rashes and ear infections to pneumonia and bloodstream infections. The severity depends on where the infection is and the person’s overall health. So, while it’s a common germ, it’s one we need to keep an eye on, especially in clinical settings. The ability of Pseudomonas aeruginosa to adapt and survive in various environments is a key reason for its classification and the challenges it presents in healthcare. The bacteria’s resilience is a significant factor in how it’s classified, studied, and treated in different clinical situations. This adaptability underscores the need for continuous research and understanding of Pseudomonas aeruginosa to combat its effects effectively. That’s why understanding Pseudomonas aeruginosa classification is so important – it helps us know where it comes from, how it spreads, and how to best treat infections.
Characteristics of Pseudomonas Aeruginosa
Let’s chat a bit about what makes Pseudomonas aeruginosa unique. It’s got some pretty cool (and sometimes problematic) features. First off, it’s a rod-shaped bacterium with a single polar flagellum, which helps it move around – that’s why it can spread in water and on surfaces. It’s non-fermentative, meaning it can’t break down sugars in the way some other bacteria can. Instead, it uses other nutrients. One of the telltale signs of Pseudomonas aeruginosa is its production of pigments. It often produces a blue-green pigment called pyocyanin and a yellow pigment called pyoverdine. This combination can give infected wounds a characteristic bluish-green color, which can help doctors identify the infection. It also has a strong natural resistance to many antibiotics. This is a big deal, as it makes infections harder to treat. This antibiotic resistance is a major concern, and scientists are constantly working on new ways to fight it. Furthermore, Pseudomonas aeruginosa is highly adaptable and can form biofilms – communities of bacteria that stick together and are harder to kill. These biofilms can form on medical devices like catheters and can protect the bacteria from antibiotics. This adaptability, pigment production, antibiotic resistance, and biofilm formation are all key aspects of its classification and why it’s such a well-studied organism. These characteristics affect how it is classified within the bacterial world and how we approach treatment strategies.
Classification of Pseudomonas Aeruginosa
Okay, let’s get down to the nitty-gritty of Pseudomonas aeruginosa classification . From a scientific standpoint, it’s classified in a pretty standard way, like other living organisms. Here’s a breakdown:
- Domain: Bacteria – It belongs to the domain of all bacteria.
- Phylum: Proteobacteria – A large and diverse group of bacteria.
- Class: Gammaproteobacteria – A class within the Proteobacteria.
- Order: Pseudomonadales – This order includes bacteria that are rod-shaped and have polar flagella.
- Family: Pseudomonadaceae – The family that includes the genus Pseudomonas .
- Genus: Pseudomonas – This is where it gets its name, and includes many species of bacteria that are found in various environments.
- Species: Pseudomonas aeruginosa – This is the specific species we’re talking about.
So, Pseudomonas aeruginosa is a specific type within the broader Pseudomonas genus. It’s a member of the Gammaproteobacteria class, which is a big group. This Pseudomonas aeruginosa classification helps scientists understand its relationships to other bacteria, its evolutionary history, and how it might behave in different environments. This classification helps scientists and doctors to be able to better understand and target this bacteria. It helps in developing targeted treatments, understanding its behavior, and preventing its spread. It’s like a family tree for bacteria, showing how different types are related. Its classification helps researchers and healthcare professionals to better understand its characteristics and develop effective strategies for diagnosis and treatment.
Why is Classification Important?
So, why does any of this classification stuff matter? Well, knowing where Pseudomonas aeruginosa fits in the bacterial family tree helps us in several ways. Firstly, it helps scientists understand how it’s related to other bacteria. This knowledge can provide insights into how it evolved, its genetic makeup, and how it might interact with other organisms. Secondly, classification helps us identify it more easily in the lab. By knowing its specific characteristics, like its Gram-negative cell wall and its ability to produce certain pigments, we can use specific tests to confirm its presence in a sample. Thirdly, classification helps us understand how it spreads and how to prevent it. We can trace its origins and identify the risk factors. For example, if it’s found in a hospital, we can focus on cleaning and sterilization measures. Ultimately, the classification is a tool that allows scientists, doctors, and public health officials to understand and fight against this bacterium. The classification is essential in tracking outbreaks, developing new antibiotics, and improving our ability to control infections. Without this information, we’d be flying blind, and that’s not a good place to be when dealing with infections. The insights gained from the classification of Pseudomonas aeruginosa are essential for its management and control, making it a critical aspect of healthcare and scientific research.
Types of Pseudomonas Aeruginosa
Now, let’s look at the different strains or types of Pseudomonas aeruginosa . While they all belong to the same species, they can differ slightly in their genetic makeup and the kinds of infections they cause. There’s a wide variety of strains, which contribute to the bacteria’s adaptability and ability to cause a range of infections. Scientists and researchers often study these different types to understand how they might behave differently and how to treat the infections they cause. Here’s a quick overview:
- Clinical Isolates: These are strains of Pseudomonas aeruginosa that are actually found in patients. These can vary depending on the type of infection (e.g., lung, skin, bloodstream) and the patient’s condition. The specific strains of Pseudomonas aeruginosa isolated from patients are classified based on the type of infection they cause and their genetic makeup. This information is crucial for selecting appropriate treatments and managing infections effectively. Different strains exhibit varying levels of antibiotic resistance, so knowing the type can inform treatment decisions. These strains are often characterized by their specific antibiotic resistance profiles, which helps guide treatment choices in clinical settings. Understanding the characteristics of these clinical isolates is vital for effective patient care.
- Environmental Strains: These are strains that are found in the environment – in soil, water, etc. These types are less likely to cause infections in humans, but they still help us understand where the bacteria comes from and how it spreads.
- Antibiotic-Resistant Strains: This is a big one. Due to the overuse of antibiotics, many strains of Pseudomonas aeruginosa have developed resistance to multiple drugs. Some strains are even resistant to nearly all available antibiotics, making these infections very difficult to treat. These antibiotic-resistant strains are a major concern in healthcare, leading to increased morbidity, mortality, and healthcare costs. The classification of these resistant strains is key for tracking their spread and developing strategies to combat them. Scientists are constantly working on ways to overcome antibiotic resistance, such as developing new antibiotics or using existing ones in new ways. Identifying and classifying these resistant strains helps inform treatment choices and infection control measures. Understanding the genetic mechanisms behind antibiotic resistance is crucial for developing effective strategies to combat the spread of these resistant strains.
- Mucoid Strains: Some strains of Pseudomonas aeruginosa produce a thick, slimy substance called alginate. This substance helps the bacteria form biofilms, which protect them from antibiotics and the immune system. These strains are often associated with chronic lung infections in people with cystic fibrosis. The mucoid phenotype is a key feature of Pseudomonas aeruginosa in people with cystic fibrosis. The production of alginate contributes to the persistence of infection and the challenges in treatment. These strains are identified based on their mucoid appearance and are classified according to the genes responsible for alginate production. Understanding these types is essential for managing the long-term health of those with cystic fibrosis.
Importance of Identifying Types
Why is it essential to know about these various types? Well, because each type can behave differently. Understanding the specific type of Pseudomonas aeruginosa causing an infection helps healthcare providers determine the best treatment. For example, knowing the antibiotic resistance profile of a strain is essential for choosing the right antibiotics. Also, identifying the type of strain can help track the source of an infection, especially in hospitals, helping to prevent further spread. The ability to identify different types allows doctors to tailor treatments and provides a better chance of a successful outcome. It is crucial for effectively managing infections, implementing infection control measures, and developing new therapeutic strategies. This targeted approach is much more effective than a one-size-fits-all approach. The knowledge of the different types of Pseudomonas aeruginosa helps to tailor effective treatment strategies, optimize patient care, and control the spread of these infections.
Conclusion
So, there you have it, folks! A rundown of the classification of Pseudomonas aeruginosa and some of the different types you might encounter. It’s a complex topic, but hopefully, you’ve got a better understanding of this common but sometimes tricky bacterium. Remember, it’s essential to understand its characteristics, its classification, and the different types of infections it can cause. By knowing more about Pseudomonas aeruginosa , we can better prevent, diagnose, and treat the infections it causes. If you have any further questions, feel free to ask! Remember, being informed is the first step in protecting yourself and others from this opportunistic pathogen. Stay safe, and stay informed, and always consult with a healthcare professional for any health concerns!